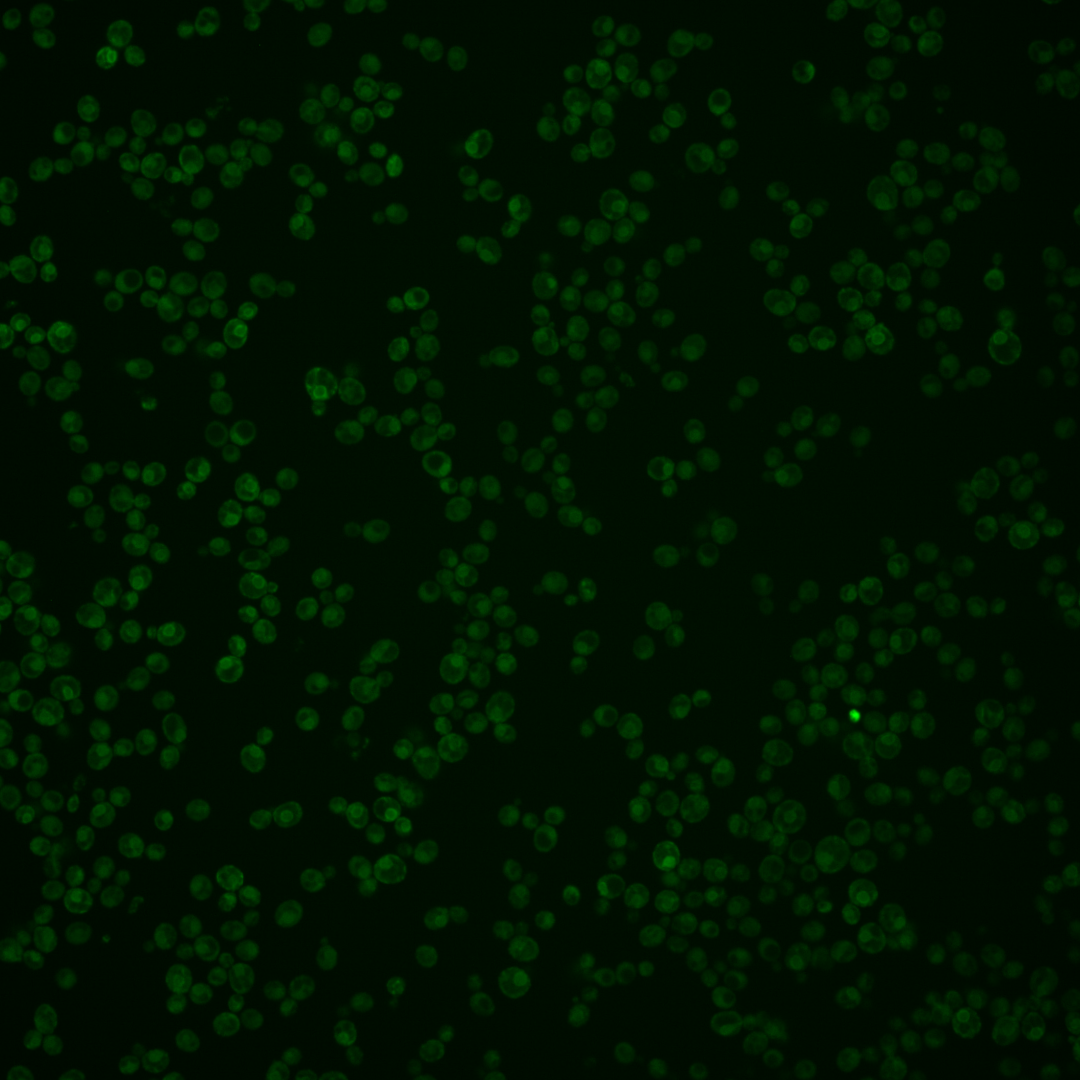
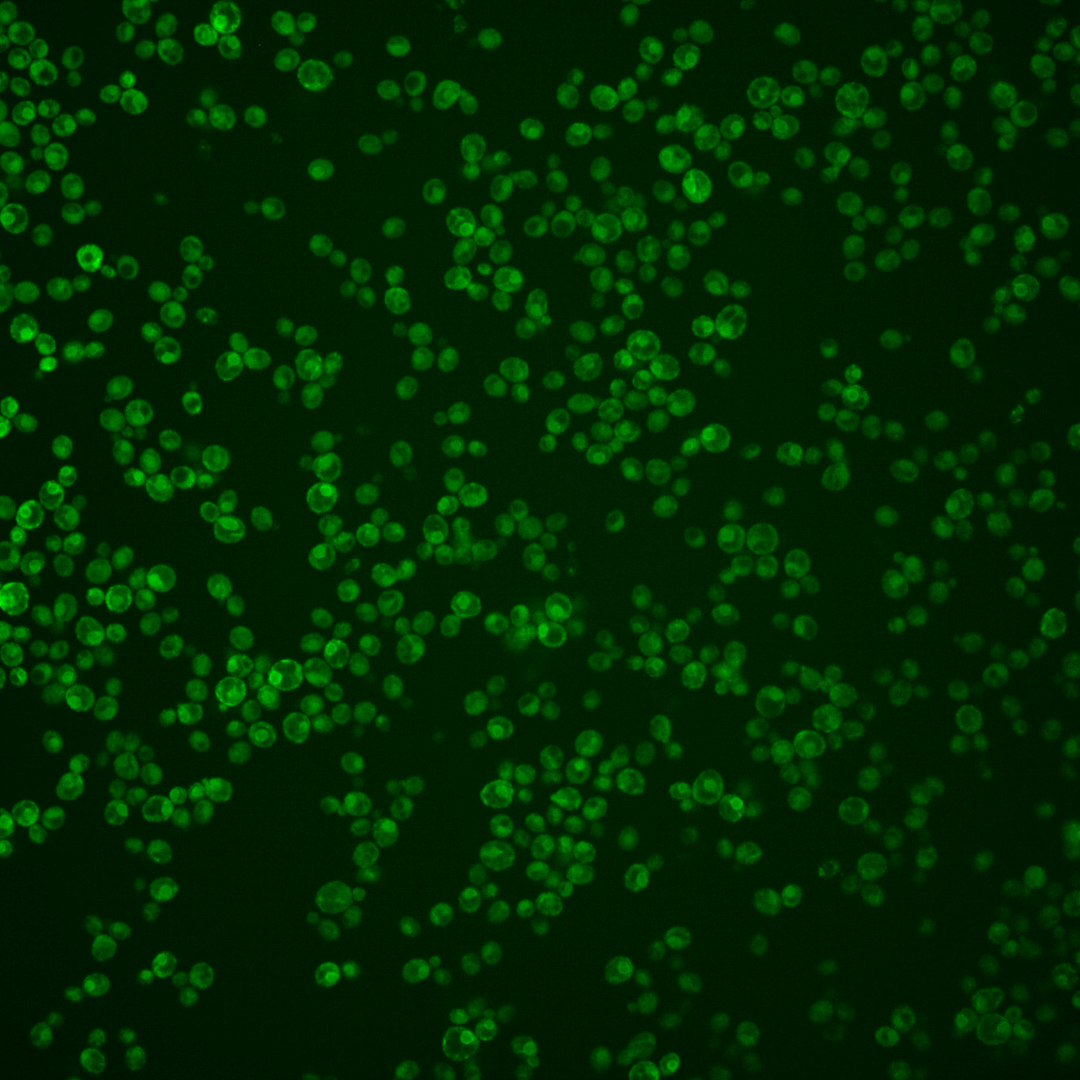

| Standard name | |
|---|---|
| Human Ortholog | |
| Description | Catalytic subunit of the histone acetyltransferase complex (NuA4); acetylates four conserved internal lysines of histone H4 N-terminal tail and can acetylate histone H2A; master regulator of cellular acetylation balance; required for cell cycle progression and transcriptional silencing at the rDNA locus and regulation of autophagy; human ortholog TIP60/KAT5 is implicated in cancer and other diseases, functionally complements lethality of the esa1 null mutation |
Micrographs




















































































Sub-cellular Localization
Yeast GFP Assignment
Protein Abundance
Localization Change
External localization resources
| ensLOC | DeepLoc | |||||||||||||||||||||||
|---|---|---|---|---|---|---|---|---|---|---|---|---|---|---|---|---|---|---|---|---|---|---|---|---|
| Localization | WT1 | WT2 | WT3 | RAP60 | RAP140 | RAP220 | RAP300 | RAP380 | RAP460 | RAP540 | RAP620 | RAP700 | HU80 | HU120 | HU160 | rpd3Δ_1 | rpd3Δ_2 | rpd3Δ_3 | WT1 | WT2 | WT3 | AF100 | AF140 | AF180 |
| Cortical Patches | 5 | 2 | 12 | 12 | 20 | 16 | 22 | 18 | 18 | 31 | 18 | 20 | 6 | 5 | 1 | 19 | 20 | 15 | 8 | 3 | 11 | 3 | 12 | 17 |
| Bud | 5 | 1 | 4 | 9 | 7 | 2 | 14 | 10 | 18 | 21 | 24 | 20 | 1 | 2 | 1 | 5 | 6 | 1 | 10 | 3 | 4 | 2 | 7 | 19 |
| Bud Neck | 0 | 0 | 1 | 1 | 0 | 0 | 0 | 0 | 0 | 0 | 0 | 0 | 0 | 0 | 1 | 0 | 0 | 0 | 2 | 0 | 2 | 2 | 3 | 4 |
| Bud Site | 0 | 0 | 0 | 0 | 0 | 0 | 1 | 0 | 0 | 1 | 2 | 1 | 0 | 0 | 0 | 0 | 0 | 0 | – | – | – | – | – | – |
| Cell Periphery | 3 | 0 | 15 | 12 | 11 | 11 | 26 | 28 | 19 | 35 | 27 | 47 | 16 | 17 | 35 | 54 | 52 | 49 | 2 | 0 | 5 | 3 | 9 | 7 |
| Cytoplasm | 94 | 25 | 75 | 58 | 79 | 52 | 68 | 65 | 87 | 92 | 99 | 124 | 133 | 210 | 301 | 78 | 72 | 51 | 23 | 12 | 13 | 34 | 109 | 127 |
| Endoplasmic Reticulum | 110 | 18 | 131 | 44 | 53 | 146 | 198 | 158 | 124 | 145 | 50 | 111 | 117 | 106 | 88 | 4 | 4 | 4 | 196 | 48 | 196 | 89 | 172 | 186 |
| Endosome | 1 | 0 | 1 | 2 | 6 | 0 | 5 | 0 | 3 | 0 | 1 | 2 | 3 | 0 | 0 | 1 | 1 | 0 | 0 | 0 | 1 | 1 | 5 | 2 |
| Golgi | 1 | 0 | 1 | 0 | 5 | 0 | 0 | 0 | 0 | 0 | 0 | 0 | 0 | 0 | 0 | 8 | 12 | 14 | 2 | 0 | 1 | 0 | 0 | 1 |
| Mitochondria | 34 | 1 | 8 | 35 | 32 | 62 | 110 | 72 | 77 | 128 | 97 | 129 | 0 | 0 | 0 | 3 | 5 | 5 | 14 | 3 | 8 | 11 | 19 | 14 |
| Nucleus | 0 | 0 | 1 | 0 | 0 | 0 | 2 | 0 | 1 | 0 | 2 | 1 | 0 | 4 | 0 | 1 | 0 | 1 | 0 | 0 | 0 | 2 | 1 | 1 |
| Nuclear Periphery | 0 | 0 | 1 | 2 | 1 | 2 | 8 | 6 | 3 | 6 | 0 | 9 | 0 | 0 | 0 | 0 | 0 | 0 | 0 | 2 | 0 | 0 | 0 | 0 |
| Nucleolus | 0 | 0 | 0 | 0 | 0 | 0 | 0 | 0 | 0 | 0 | 1 | 0 | 0 | 0 | 0 | 0 | 0 | 0 | 0 | 0 | 0 | 0 | 0 | 0 |
| Peroxisomes | 0 | 0 | 0 | 0 | 1 | 1 | 0 | 0 | 1 | 0 | 0 | 0 | 0 | 0 | 0 | 0 | 0 | 0 | 0 | 0 | 0 | 0 | 0 | 0 |
| SpindlePole | 0 | 0 | 1 | 0 | 1 | 1 | 0 | 0 | 1 | 1 | 1 | 0 | 2 | 0 | 0 | 2 | 0 | 0 | 0 | 0 | 0 | 1 | 0 | 0 |
| Vac/Vac Membrane | 16 | 1 | 7 | 4 | 10 | 6 | 10 | 21 | 29 | 29 | 24 | 23 | 11 | 8 | 15 | 21 | 9 | 18 | 4 | 5 | 3 | 11 | 21 | 21 |
| Unique Cell Count | 229 | 44 | 218 | 132 | 172 | 237 | 354 | 299 | 308 | 384 | 262 | 374 | 265 | 319 | 394 | 170 | 147 | 133 | 271 | 80 | 251 | 166 | 373 | 410 |
| Labelled Cell Count | 269 | 48 | 258 | 179 | 226 | 299 | 464 | 378 | 381 | 489 | 346 | 487 | 289 | 352 | 442 | 196 | 181 | 158 | 271 | 80 | 251 | 166 | 373 | 410 |
Yeast GFP Assignment
Protein Abundance
| Screen | WT1 | WT2 | WT3 | RAP60 | RAP140 | RAP220 | RAP300 | RAP380 | RAP460 | RAP540 | RAP620 | RAP700 | HU80 | HU120 | HU160 | rpd3Δ_1 | rpd3Δ_2 | rpd3Δ_3 | AF100 | AF140 | AF180 |
|---|---|---|---|---|---|---|---|---|---|---|---|---|---|---|---|---|---|---|---|---|---|
| Mean Cell GFP Intensity (1e-4) | 6.0 | 7.9 | 6.6 | 6.7 | 8.2 | 8.8 | 8.3 | 8.0 | 7.9 | 7.5 | 7.1 | 7.0 | 8.5 | 7.5 | 6.8 | 18.3 | 19.4 | 20.6 | 8.3 | 8.2 | 8.1 |
| Std Deviation (1e-4) | 1.6 | 2.5 | 1.6 | 2.1 | 3.4 | 2.5 | 2.5 | 2.3 | 2.4 | 2.5 | 2.8 | 2.5 | 2.6 | 1.8 | 1.6 | 9.4 | 9.5 | 11.1 | 2.0 | 1.7 | 1.9 |
| Intensity Change (Log2) | – | – | – | 0.02 | 0.3 | 0.41 | 0.34 | 0.28 | 0.26 | 0.18 | 0.11 | 0.09 | 0.37 | 0.19 | 0.04 | 1.47 | 1.55 | 1.64 | 0.33 | 0.3 | 0.29 |
Localization Change
| Localization | RAP60 | RAP140 | RAP220 | RAP300 | RAP380 | RAP460 | RAP540 | RAP620 | RAP700 | HU80 | HU120 | HU160 | rpd3Δ_1 | rpd3Δ_2 | rpd3Δ_3 |
|---|---|---|---|---|---|---|---|---|---|---|---|---|---|---|---|
| Cortical Patches | 1.3 | 2.2 | 0.6 | 0.3 | 0.2 | 0.2 | 1.2 | 0.6 | -0.1 | -1.9 | -2.6 | 0 | 2.0 | 2.7 | 2.0 |
| Bud | 0 | 0 | 0 | 1.4 | 1.0 | 2.3 | 2.1 | 3.4 | 2.1 | 0 | 0 | 0 | 0 | 0 | 0 |
| Bud Neck | 0 | 0 | 0 | 0 | 0 | 0 | 0 | 0 | 0 | 0 | 0 | 0 | 0 | 0 | 0 |
| Bud Site | 0 | 0 | 0 | 0 | 0 | 0 | 0 | 0 | 0 | 0 | 0 | 0 | 0 | 0 | 0 |
| Cell Periphery | 0.8 | -0.2 | -1.0 | 0.2 | 1.0 | -0.3 | 1.0 | 1.3 | 2.2 | -0.4 | -0.7 | 0.9 | 6.4 | 6.9 | 7.1 |
| Cytoplasm | 1.8 | 2.3 | -3.0 | -4.1 | -3.2 | -1.5 | -2.8 | 0.8 | -0.3 | 3.5 | 7.2 | 10.2 | 2.3 | 2.8 | 0.7 |
| Endoplasmic Reticulum | -4.9 | -5.8 | 0.3 | -1.0 | -1.6 | -4.5 | -5.3 | -9.2 | -7.3 | -3.5 | -6.2 | -9.3 | -11.8 | -11.1 | -10.7 |
| Endosome | 0 | 0 | 0 | 0 | 0 | 0 | 0 | 0 | 0 | 0 | 0 | 0 | 0 | 0 | 0 |
| Golgi | 0 | 0 | 0 | 0 | 0 | 0 | 0 | 0 | 0 | 0 | 0 | 0 | 0 | 3.9 | 4.5 |
| Mitochondria | 6.3 | 4.8 | 6.6 | 7.9 | 6.3 | 6.5 | 8.4 | 8.8 | 8.6 | 0 | 0 | 0 | 0 | -0.1 | 0 |
| Nucleus | 0 | 0 | 0 | 0 | 0 | 0 | 0 | 0 | 0 | 0 | 0 | 0 | 0 | 0 | 0 |
| Nuclear Periphery | 0 | 0 | 0 | 0 | 0 | 0 | 0 | 0 | 0 | 0 | 0 | 0 | 0 | 0 | 0 |
| Nucleolus | 0 | 0 | 0 | 0 | 0 | 0 | 0 | 0 | 0 | 0 | 0 | 0 | 0 | 0 | 0 |
| Peroxisomes | 0 | 0 | 0 | 0 | 0 | 0 | 0 | 0 | 0 | 0 | 0 | 0 | 0 | 0 | 0 |
| SpindlePole | 0 | 0 | 0 | 0 | 0 | 0 | 0 | 0 | 0 | 0 | 0 | 0 | 0 | 0 | 0 |
| Vacuole | 0 | 1.3 | -0.4 | -0.3 | 1.9 | 2.8 | 2.2 | 2.6 | 1.6 | 0.5 | -0.5 | 0.4 | 3.5 | 1.3 | 3.6 |
External localization resources
Images






























Protein Concentration and Protein Localization Data
| R1 | R2 | R3 | ||||||||||||||||
|---|---|---|---|---|---|---|---|---|---|---|---|---|---|---|---|---|---|---|
| G1 Pre-START | G1 Post-START | S/G2 | Metaphase | Anaphase | Telophase | G1 Pre-START | G1 Post-START | S/G2 | Metaphase | Anaphase | Telophase | G1 Pre-START | G1 Post-START | S/G2 | Metaphase | Anaphase | Telophase | |
| Concentration | 5.2277 | 6.5775 | 4.7226 | 4.9375 | 3.705 | 7.0321 | 5.204 | 6.1648 | 4.3377 | 3.5555 | 2.7209 | 5.6702 | 4.8794 | 5.7095 | 3.2798 | 2.478 | 0.6044 | 5.0466 |
| Actin | 0.003 | 0.0043 | 0.006 | 0.0088 | 0.0088 | 0.0067 | 0.038 | 0.0063 | 0.0088 | 0.0224 | 0.0221 | 0.001 | 0.0235 | 0.002 | 0.0231 | 0.0513 | 0.0173 | 0.003 |
| Bud | 0.0002 | 0.0064 | 0.0014 | 0.0074 | 0.0029 | 0.0002 | 0.001 | 0.002 | 0.0018 | 0.0006 | 0.0049 | 0.0002 | 0.0004 | 0.0002 | 0.0004 | 0.0051 | 0.0017 | 0.0002 |
| Bud Neck | 0.0002 | 0.0006 | 0.0007 | 0.0024 | 0.0022 | 0.0021 | 0.0012 | 0.0007 | 0.0012 | 0.0012 | 0.0012 | 0.0093 | 0.0028 | 0.0002 | 0.0007 | 0.0035 | 0.0007 | 0.0033 |
| Bud Periphery | 0.0016 | 0.0161 | 0.0056 | 0.0088 | 0.0139 | 0.0008 | 0.004 | 0.0037 | 0.0083 | 0.001 | 0.0545 | 0.0008 | 0.0013 | 0.0009 | 0.0009 | 0.0089 | 0.0145 | 0.001 |
| Bud Site | 0.0011 | 0.0132 | 0.0036 | 0.006 | 0.0007 | 0.0026 | 0.0027 | 0.0207 | 0.013 | 0.0014 | 0.0023 | 0.0002 | 0.002 | 0.0012 | 0.0038 | 0.0043 | 0.0006 | 0.0002 |
| Cell Periphery | 0.0028 | 0.0133 | 0.0059 | 0.0093 | 0.0077 | 0.0025 | 0.0067 | 0.0075 | 0.005 | 0.0018 | 0.0026 | 0.0014 | 0.0023 | 0.0083 | 0.0033 | 0.005 | 0.0056 | 0.0019 |
| Cytoplasm | 0.1666 | 0.1775 | 0.2324 | 0.2117 | 0.3273 | 0.1431 | 0.1187 | 0.2565 | 0.2402 | 0.2269 | 0.2661 | 0.2328 | 0.09 | 0.161 | 0.1863 | 0.261 | 0.4732 | 0.1758 |
| Cytoplasmic Foci | 0.0136 | 0.0033 | 0.011 | 0.0083 | 0.0137 | 0.0065 | 0.013 | 0.0042 | 0.0097 | 0.0135 | 0.0117 | 0.0068 | 0.013 | 0.0029 | 0.0126 | 0.0257 | 0.0127 | 0.0071 |
| Eisosomes | 0.0002 | 0.0004 | 0.0004 | 0.0007 | 0.0008 | 0.0002 | 0.0019 | 0.0002 | 0.0002 | 0.0003 | 0.0003 | 0 | 0.0003 | 0.0001 | 0.0002 | 0.0007 | 0.0004 | 0 |
| Endoplasmic Reticulum | 0.6756 | 0.6554 | 0.5961 | 0.551 | 0.4791 | 0.7622 | 0.6279 | 0.602 | 0.583 | 0.6122 | 0.4061 | 0.689 | 0.7159 | 0.7772 | 0.6729 | 0.4552 | 0.2791 | 0.7453 |
| Endosome | 0.0183 | 0.005 | 0.0092 | 0.02 | 0.007 | 0.0119 | 0.059 | 0.0109 | 0.02 | 0.0227 | 0.0407 | 0.0097 | 0.0345 | 0.0051 | 0.0186 | 0.0237 | 0.0445 | 0.0147 |
| Golgi | 0.0035 | 0.0011 | 0.0024 | 0.0082 | 0.0029 | 0.004 | 0.0208 | 0.0013 | 0.0066 | 0.016 | 0.011 | 0.0008 | 0.0086 | 0.003 | 0.0036 | 0.0072 | 0.0067 | 0.0028 |
| Lipid Particles | 0.0271 | 0.0061 | 0.012 | 0.0107 | 0.0068 | 0.0054 | 0.03 | 0.0103 | 0.0129 | 0.0125 | 0.0437 | 0.0058 | 0.0192 | 0.012 | 0.0095 | 0.0116 | 0.0596 | 0.0098 |
| Mitochondria | 0.0039 | 0.0038 | 0.0009 | 0.0098 | 0.0028 | 0.0017 | 0.0254 | 0.0007 | 0.0083 | 0.006 | 0.0344 | 0.0006 | 0.0135 | 0.0046 | 0.002 | 0.0033 | 0.0073 | 0.0007 |
| None | 0.0618 | 0.0706 | 0.0893 | 0.0883 | 0.0862 | 0.0367 | 0.0066 | 0.0411 | 0.0402 | 0.0137 | 0.0161 | 0.0195 | 0.0199 | 0.0023 | 0.0329 | 0.0841 | 0.0376 | 0.0174 |
| Nuclear Periphery | 0.0107 | 0.0097 | 0.0103 | 0.0109 | 0.0051 | 0.0072 | 0.0166 | 0.0149 | 0.0137 | 0.0225 | 0.0154 | 0.0089 | 0.0258 | 0.0109 | 0.011 | 0.0154 | 0.0146 | 0.0073 |
| Nucleolus | 0.0002 | 0.0006 | 0.0002 | 0.0013 | 0.0005 | 0.0001 | 0.0005 | 0.0002 | 0.0003 | 0.0002 | 0.002 | 0.0001 | 0.0007 | 0 | 0.0002 | 0.0017 | 0.0005 | 0.0001 |
| Nucleus | 0.0015 | 0.0031 | 0.0021 | 0.0077 | 0.0026 | 0.0014 | 0.0034 | 0.0032 | 0.0061 | 0.0061 | 0.0254 | 0.0024 | 0.0036 | 0.0012 | 0.0019 | 0.0043 | 0.0023 | 0.0015 |
| Peroxisomes | 0.0029 | 0.0002 | 0.0005 | 0.0003 | 0.0164 | 0.0002 | 0.0056 | 0.0001 | 0.0058 | 0.0076 | 0.0104 | 0.0031 | 0.0103 | 0.0001 | 0.0021 | 0.0036 | 0.0071 | 0.0012 |
| Punctate Nuclear | 0.0013 | 0.0017 | 0.0016 | 0.016 | 0.0046 | 0.0005 | 0.0038 | 0.0012 | 0.0025 | 0.005 | 0.0091 | 0.0009 | 0.0041 | 0.0003 | 0.0066 | 0.0141 | 0.0076 | 0.001 |
| Vacuole | 0.0037 | 0.0071 | 0.0076 | 0.0099 | 0.0074 | 0.0036 | 0.0104 | 0.0098 | 0.0109 | 0.0052 | 0.0133 | 0.0061 | 0.006 | 0.006 | 0.0065 | 0.0089 | 0.0051 | 0.0052 |
| Vacuole Periphery | 0.0005 | 0.0006 | 0.0008 | 0.0026 | 0.0005 | 0.0005 | 0.0028 | 0.0023 | 0.0014 | 0.001 | 0.0069 | 0.0006 | 0.0023 | 0.0005 | 0.0008 | 0.0014 | 0.0014 | 0.0005 |
Sequencing Data
| R1 | R2 | |||||||||
|---|---|---|---|---|---|---|---|---|---|---|
| G1 Post-START | S/G2 | Metaphase | Anaphase | Telophase | G1 Post-START | S/G2 | Metaphase | Anaphase | Telophase | |
| Gene Expression | 14.844 | 13.2696 | 10.3937 | 16.7812 | 7.4845 | 9.8905 | 18.2619 | 16.6018 | 16.019 | 19.2911 |
| Translational Efficiency | 1.0241 | 1.0471 | 1.1689 | 0.9158 | 2.0703 | 1.6649 | 0.8871 | 0.8508 | 0.999 | 0.9484 |
Hit Data
| Dataset | Hit |
|---|---|
| Protein Concentration | ✔ |
| Protein Localization | ✔ |
| Gene Expression | ✘ |
| Translational Efficiency | ✘ |
Endocytosis
| Temp | Actin Patch (Sac6-tdTomato) | Cortical Patch (Sla1-GFP) | Late Endosome (Snf7-GFP) | Vacuole (Vph1-GFP) |
|---|---|---|---|---|
| 37℃ | ||||
| RT |
Cell Cycle Omics
CYCLoPs (Esa1-GFP)
| Gene / Allele | Actin Patch (Sac6-tdTomato) | Cortical Patch (Sla1-GFP) | Late Endosome (Snf7-GFP) | Vacuole (Sac6-tdTomato) |
|---|
| Gene | Images |
|---|
| Gene | Images |
|---|
Images are not yet available
Images are not yet available